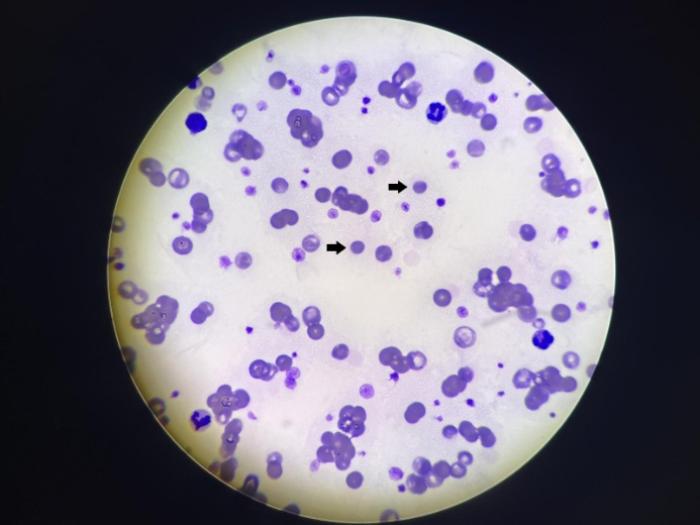

Técnicas de diagnóstico en anemia hemolítica inmunomediada en perros
Resumen breve
La anemia hemolítica inmunomediada (AHIM) es una de las enfermedades hematológicas más comunes en pequeños animales y se caracteriza por la destrucción acelerada de eritrocitos debido a anticuerpos dirigidos contra ellos. Esta hemólisis puede ser intravascular, mediada por el complemento, o extravascular, más frecuente, a través del sistema mononuclear fagocítico. La enfermedad puede ser primaria, cuando los anticuerpos reconocen directamente antígenos de membrana eritrocitaria, o secundaria,…Índice de contenidos
Resumen
La anemia hemolítica inmunomediada (AHIM) es una de las enfermedades hematológicas más comunes en pequeños animales y se caracteriza por la destrucción acelerada de eritrocitos debido a anticuerpos dirigidos contra ellos. Esta hemólisis puede ser intravascular, mediada por el complemento, o extravascular, más frecuente, a través del sistema mononuclear fagocítico. La enfermedad puede ser primaria, cuando los anticuerpos reconocen directamente antígenos de membrana eritrocitaria, o secundaria, asociada a patologías que alteran dicha membrana o generan antígenos nuevos. En perros, predominan las inmunoglobulinas IgG, mientras que en gatos son más frecuentes las IgM. La AHIM se presenta con mayor frecuencia en hembras entre dos y ocho años y ciertas razas muestran predisposición genética.
Los signos clínicos dependen de la rapidez y severidad del proceso e incluyen letargo, anorexia, vómitos, diarrea y debilidad. En la exploración física suelen observarse taquicardia, taquipnea, fiebre, mucosas pálidas o ictéricas y hepatosplenomegalia. Entre las complicaciones destacan la coagulación intravascular diseminada y el tromboembolismo pulmonar.
El diagnóstico requiere integrar la clínica con diversas pruebas laboratoriales. El hemograma suele mostrar anemia regenerativa, leucocitosis y, en ocasiones, trombocitopenia. La prueba de aglutinación en solución salina permite diferenciar auténtica aglutinación inmunomediada del rouleaux y posee alta especificidad. La prueba de Coombs directa detecta anticuerpos y complemento unidos a los eritrocitos, aunque su sensibilidad es limitada. El frotis sanguíneo es esencial para identificar esferocitos —clave diagnóstica en perros—, policromasia, anisocitosis y aglutinación. Otras pruebas complementarias incluyen la detección de hiperbilirrubinemia, hemoglobinemia, hemoglobinuria y la presencia de eritrocitos fantasmas, indicadores de hemólisis activa.
En conjunto, estas herramientas permiten confirmar la hemólisis y determinar si el mecanismo es inmunomediado, paso fundamental para establecer un tratamiento adecuado y descartar causas secundarias. El diagnóstico definitivo se basa en la combinación coherente de múltiples evidencias clínicas y laboratoriales.
Introducción
La anemia hemolítica inmunomediada (AHIM) constituye una de las alteraciones hematológicas más prevalentes en la medicina de pequeños animales. Se trata de un síndrome clínico caracterizado por la producción desregulada de anticuerpos dirigidos contra los eritrocitos propios. Esta condición provoca una destrucción acelerada de los hematíes, ya sea a nivel intravascular —mediada por el complemento— o extravascular —más habitual— a través del sistema mononuclear fagocítico del bazo, hígado y médula ósea, derivando en ambos casos en un estado anémico.
La etiología puede ser primaria o secundaria:
- Primaria: ocurre cuando los anticuerpos se dirigen directamente contra antígenos de membrana de los eritrocitos. Aproximadamente un 30 % de los casos se asocian a otras enfermedades autoinmunes, como el lupus eritematoso sistémico o la trombocitopenia autoinmune.
- Secundaria: surge a consecuencia de patologías subyacentes que generan la aparición de nuevos antígenos en la membrana eritrocitaria. Algunos agentes infecciosos poseen antígenos similares a los de los glóbulos rojos, de modo que los anticuerpos dirigidos contra dichos agentes pueden reaccionar también frente a la membrana eritrocitaria.
La AHIM puede clasificarse de diversas formas:
- Según el tipo de inmunoglobulina implicada: en perros, las más frecuentes son las IgG, seguidas por las IgM y, en raras ocasiones, las IgA; en gatos predominan las IgM.
- Según el tipo de hemólisis predominante: intravascular o extravascular.
La enfermedad aparece con mayor frecuencia en hembras (70 %) que en machos, habitualmente entre los 2 y los 8 años, aunque puede afectar a animales de cualquier edad. Asimismo, se ha descrito una predisposición genética en razas como Cocker Spaniel, Bichon Frisé, Pinscher miniatura, Schnauzer miniatura, Springer Spaniel inglés, Collie de pelo duro y Spitz finlandés.
Entre las complicaciones más comunes asociadas a la AHIM se encuentran la coagulación intravascular diseminada (CID) y el tromboembolismo pulmonar, cada uno con su correspondiente cuadro clínico.
La sintomatología depende de la rapidez de instauración del proceso, su gravedad y el mecanismo hemolítico implicado. Los signos clínicos más habituales incluyen letargo, vómitos, anorexia, debilidad, diarrea y depresión. El síncope o el colapso son menos frecuentes y, en algunos casos, la disnea puede constituir la primera manifestación clínica observable.
En la exploración física suelen detectarse taquicardia, taquipnea, soplo cardíaco, fiebre, mucosas pálidas o ictéricas y hepatoesplenomegalia. También pueden presentarse bilirrubinuria o hemoglobinuria. Si coexiste trombocitopenia, pueden observarse equimosis, epistaxis, melena y petequias.
El diagnóstico se basa en la integración de los hallazgos clínicos con pruebas laboratoriales como hemograma, frotis sanguíneo, identificación de esferocitos, pruebas de aglutinación y test de Coombs, junto con la exclusión de causas secundarias.
Pruebas laboratoriales en el diagnóstico de la AHIM
Hemograma
El primer paso diagnóstico consiste en determinar el tipo de anemia, diferenciando si se debe a una disminución de la eritropoyesis, a una hemorragia o a un proceso hemolítico. Al momento de la presentación clínica, la mayoría de los pacientes presentan anemia grave, con valores de hematocrito que rondan entre el 12 y el 14 %, generalmente regenerativa, evidenciada por un incremento del recuento de reticulocitos. No obstante, en fases muy tempranas o en situaciones de destrucción eritrocitaria masiva, la regeneración puede no ser inicialmente evidente, dando lugar a un patrón aparentemente no regenerativo.
Es habitual observar leucocitosis marcada, frecuentemente con neutrofilia y posible desviación a la izquierda, reflejo de la respuesta inflamatoria sistémica. Asimismo, puede detectarse trombocitopenia, ya sea por consumo, destrucción inmunomediada concurrente o por la formación de microtrombos. Este conjunto de alteraciones hematológicas orienta hacia un proceso hemolítico activo compatible con AHIM.
Prueba de aglutinación
Esta prueba se fundamenta en el principio de que la solución salina fisiológica es capaz de disgregar la formación de rouleaux —un fenómeno en el que los eritrocitos se disponen en forma de “pila de monedas” debido a alteraciones en la carga superficial o a variaciones en las proteínas plasmáticas—, pero no posee la capacidad de separar los verdaderos agregados celulares originados por la unión inmunológica entre anticuerpos y eritrocitos. Esta diferencia es crucial, ya que permite discriminar entre un artefacto frecuente y un auténtico proceso inmunomediado.
Para llevar a cabo la prueba, se deposita en un portaobjetos una mezcla compuesta por una gota de sangre entera y cuatro gotas de solución salina, tras lo cual se procede a homogeneizar suavemente la preparación para asegurar una distribución uniforme de las células. Posteriormente, la mezcla se examina en busca de evidencia de aglutinación, la cual puede manifestarse desde una apreciación macroscópica, visible directamente en la superficie del portaobjetos (Figura 1), hasta una observación más detallada mediante evaluación microscópica (Figura 2), recomendándose esta última para una confirmación más precisa.


Prueba de Coombs directa
La prueba de Coombs directa se utiliza para detectar anticuerpos (IgG, IgM) y componentes del complemento adheridos a la superficie de los eritrocitos. El reactivo específico provoca aglutinación cuando estas moléculas están presentes, lo que indica un resultado positivo. Aunque es una herramienta útil para confirmar anemia hemolítica inmunomediada (AHIM), su sensibilidad es muy baja, por lo que pueden presentarse falsos negativos. Por esta razón, se recomienda complementarla con otras pruebas diagnósticas como la búsqueda de esferocitos y la prueba de aglutinación.
Frotis sanguíneo
El frotis sanguíneo es una herramienta diagnóstica fundamental en la evaluación de perros con sospecha de anemia hemolítica inmunomediada. Permite la identificación directa de alteraciones morfológicas eritrocitarias.
Esferocitos
Los esferocitos son eritrocitos que han perdido su morfología bicóncava habitual y han adoptado una forma completamente esférica como consecuencia de una reducción parcial de su membrana plasmática. En un frotis sanguíneo adecuadamente preparado, estas células se identifican como hematíes de menor tamaño, más densos y carentes de la palidez central típica de los eritrocitos normales (Figura 3). Esta modificación estructural surge debido a que la pérdida de superficie de membrana altera la relación superficie-volumen, obligando al eritrocito a adoptar una geometría más compacta y esférica.
La evaluación de esferocitos en perros anémicos debe realizarse exclusivamente en la monocapa del frotis sanguíneo, es decir, en la zona en la que los eritrocitos se encuentran distribuidos en una capa celular fina y sin solapamientos. Esto es fundamental, ya que en los márgenes del frotis o en áreas excesivamente gruesas pueden aparecer artefactos morfológicos que imitan la apariencia de esferocitos, generando interpretaciones erróneas. La correcta identificación requiere experiencia, un frotis de buena calidad, y la valoración simultánea de otros cambios compatibles con hemólisis inmunomediada.
En la especie felina, la presencia o ausencia de esferocitos carece de valor diagnóstico, ya que los eritrocitos de los gatos no muestran una palidez central visible de manera constante. Esto dificulta distinguir con certeza un esferocito verdadero de un eritrocito normal, por lo que este hallazgo no debe utilizarse como criterio para apoyar o descartar un proceso inmunomediado en gatos.
En perros, sin embargo, la detección de esferocitos en un animal con anemia regenerativa constituye un hallazgo de gran relevancia clínica. Su presencia se considera un elemento altamente sugestivo —y en muchos casos prácticamente confirmatorio— de un mecanismo de destrucción inmunomediada, especialmente cuando se observa en cantidades moderadas a abundantes y se interpreta junto con otros parámetros hematológicos y pruebas complementarias. De este modo, la esferocitosis adquiere un papel clave dentro del conjunto de evidencias utilizadas para establecer el diagnóstico de anemia hemolítica inmunomediada.
Policromasia y anisocitosis
La policromasia describe la presencia de eritrocitos con tonalidad azul-gris en el frotis sanguíneo, indicativa de células inmaduras (reticulocitos) que aún contienen ARN ribosomal. Este hallazgo refleja actividad eritropoyética aumentada, común en anemias regenerativas, hemólisis o recuperación tras hemorragia.
La anisocitosis se refiere a la variación anormal en el tamaño de los eritrocitos observada en un frotis sanguíneo. Es un hallazgo morfológico, no una enfermedad en sí misma, y suele asociarse a procesos como anemias regenerativas, ferropénicas, hemolíticas o megaloblásticas. Es frecuente en anemias regenerativas por presencia de reticulocitos (células más grandes). Se puede cuantificar mediante el parámetro RDW (Red cell Distribution Width), que indica la amplitud de distribución del tamaño eritrocitario.
Presencia de aglutinación
Puede observarse en la preparación, lo que refuerza la sospecha de hemólisis inmunomediada.
La aglutinación eritrocitaria hace referencia a la presencia de cúmulos de eritrocitos que se pegan entre ellos, creando agrupaciones irregulares que son perceptibles en un frotis sanguíneo observado microscópicamente. La disposición en "pila de monedas" (rouleaux) es diferente a este fenómeno, pues los eritrocitos en la aglutinación se agrupan desordenadamente y no en filas alineadas. La presencia de este fenómeno, refuerza la sospecha de hemólisis inmunomediada, que debe ser confirmado con la prueba de aglutinación con solución salina.
Además, el frotis permite evaluar leucocitos y plaquetas, detectando leucocitosis por neutrofilia con desviación a la izquierda, pudiendo observarse toxicidad neutrofílica (citoplasma basófilo, vacuolización, cuerpos de Döhle), indicativo de inflamación grave, o trombocitopenia. A diferencia de pruebas más complejas, el frotis es rápido, económico y aporta información inmediata que orienta el diagnóstico.
Pruebas complementarias
Hiperbilirrubinemia
Cuando no se observa una reducción de la masa funcional hepática, ni un proceso de colestasis obstructiva, ni un estado de sepsis que pueda justificar un aumento de los pigmentos biliares, la detección de hiperbilirrubinemia adquiere un valor diagnóstico relevante, ya que puede ser un indicador claro de hemólisis activa. La bilirrubina aumenta en sangre cuando la velocidad de destrucción eritrocitaria supera la capacidad del hígado para captar, conjugar y excretar este pigmento, por lo que su elevación constituye un reflejo indirecto del grado de hemólisis. Se considera evidencia suficiente de un incremento anómalo de la bilirrubina la presencia de ictericia clínicamente visible, la detección de una concentración sérica o plasmática de bilirrubina total por encima del intervalo de referencia, o, en el caso de los perros, un resultado de bilirrubina ≥ 2+ en una tira reactiva de orina, que indica un nivel de pigmento urinario inapropiadamente alto.
Es importante recordar que los hallazgos de bilirrubina deben interpretarse en conjunto con el contexto clínico y con el resto de parámetros bioquímicos, ya que la bilirrubinuria puede preceder a la aparición de ictericia y actuar como un marcador temprano de hemólisis o colestasis. En aquellas muestras que presentan hemólisis, la interpretación de los valores de bilirrubina debe hacerse con especial cautela. La hemólisis intrínseca a la muestra puede interferir en los métodos analíticos empleados para su cuantificación, generando resultados artificialmente elevados o alterados. Por ello, es fundamental considerar la calidad de la muestra, la técnica de extracción y transporte, así como la metodología específica del analizador utilizado.
Hemoglobinemia / hemoglobinuria
La hemoglobinemia puede detectarse de forma simple mediante la inspección visual del plasma, que adquiere una tonalidad rojiza o rosada debido a la presencia de hemoglobina libre, o mediante la cuantificación instrumental de este pigmento. Sin embargo, al utilizar índices automatizados para identificar hemólisis, resulta imprescindible tener en cuenta las limitaciones de cada equipo. Los instrumentos basados en espectrofotometría utilizan algoritmos propios del fabricante, por lo que los valores obtenidos no son directamente extrapolables entre diferentes analizadores.
Es fundamental subrayar que la hemoglobinemia únicamente debe interpretarse como evidencia de hemólisis real después de excluir la hemólisis producida de manera artefactual. Entre las causas más frecuentes de hemólisis in vitro se incluyen la venopunción traumática, que provoca ruptura mecánica de eritrocitos; la congelación accidental de la muestra; el almacenamiento prolongado en condiciones inadecuadas; la extracción de sangre a través de catéteres intravenosos, especialmente si no se descarta un volumen muerto suficiente; y la transferencia inapropiada de la muestra a tubos de vacío, lo que puede generar turbulencia y daño celular. La probabilidad de que ocurra hemólisis artificial aumenta considerablemente cuando los eritrocitos son intrínsecamente más frágiles, como ocurre en situaciones de lipemia marcada o en ciertas dislipidemias.
En ausencia de mioglobinuria, se considera que existe hemoglobinuria cuando la orina presenta un color rojizo o marrón que no desaparece tras la centrifugación, lo que confirma que el pigmento responsable se encuentra en solución y no asociado a células intactas. Además, un resultado positivo para hemo en la tira reactiva acompañado de un sedimento urinario sin eritrocitos intactos respalda firmemente este diagnóstico. Es recomendable realizar la evaluación utilizando una muestra urinaria fresca, debido a que, según la experiencia clínica, la lisis de eritrocitos en orina es más frecuente cuando está presenta un pH alcalino, baja densidad o características hipostenúricas, lo que puede generar confusiones diagnósticas si no se interpreta adecuadamente.
Eritrocitos fantasmas
La presencia de eritrocitos fantasma —membranas eritrocitarias vacías y translúcidas resultantes de la lisis intravascular mediada por el complemento— en un frotis realizado inmediatamente después de la extracción sanguínea constituye una prueba de hemólisis intravascular, ya que representan membranas eritrocitarias vacías tras la lisis de los hematíes.
Conclusión
A modo de conclusión, el conjunto de métodos diagnósticos empleados en la evaluación de la anemia hemolítica inmunomediada en medicina veterinaria permite no solo confirmar el carácter hemolítico del proceso, sino también discernir si existe un mecanismo inmunomediado subyacente, lo cual resulta esencial para establecer un tratamiento adecuado y un pronóstico realista.
El hemograma, el frotis sanguíneo y las pruebas complementarias como la detección de hiperbilirrubinemia, hemoglobinemia o hemoglobinuria constituyen herramientas fundamentales para demostrar la existencia de hemólisis, ya que evidencian signos indirectos de destrucción eritrocitaria acelerada, como la anemia regenerativa, la policromasia, la anisocitosis, la ictericia o la presencia de pigmentos circulantes.
Sin embargo, estas pruebas, aunque orientadoras, no discriminan por sí mismas la causa de la hemólisis. En cambio, pruebas como la aglutinación persistente en solución salina, la identificación de esferocitos en el frotis sanguíneo y la prueba de Coombs directa se consideran métodos clave para demostrar un origen inmunomediado, pues permiten detectar interacciones anómalas entre anticuerpos y eritrocitos, manifestadas mediante fijación de inmunoglobulinas, pérdida de superficie celular o formación de agregados eritrocitarios.
La diferenciación entre ambas categorías —pruebas que confirman hemólisis y pruebas que evidencian destrucción inmunomediada— es imprescindible para evitar diagnósticos erróneos y descartar causas secundarias como hemoparásitos, neoplasias o procesos inflamatorios severos.
En conjunto, la integración sistemática de estos hallazgos clínicos, hematológicos y bioquímicos proporciona un abordaje diagnóstico robusto y coherente, reafirmando la importancia de emplear un enfoque multifactorial en el reconocimiento de la AHIM, dado que ningún método aislado posee sensibilidad y especificidad absolutas. Así, el diagnóstico definitivo surge de la convergencia de múltiples evidencias complementarias que, interpretadas de manera crítica y contextualizada, permiten establecer con seguridad la presencia de hemólisis inmunomediada y orientar de forma precisa las decisiones terapéuticas.
Bibliografía
- Klag AR, Giger U, Shofer FS; Idiopathic immune-mediated hemolytic anemia in dogs: 42 cases (1986-1990); Journal of the American Veterinary Medical Association; 1993; 202(5):783-788.
- Day MJ; Immune-mediated hemolytic anemia: pathogenesis, diagnosis, and treatment; Journal of Small Animal Practice; 1996; 37(11):523-534.
- Duval D, Giger U; Vaccine-associated immune-mediated hemolytic anemia in the dog; Journal of Veterinary Internal Medicine; 1996; 10(5):290-295.
- Reimer ME, Troy GC, Warnick LD; Immune-mediated hemolytic anemia: 70 cases (1988-1996); Journal of the American Animal Hospital Association; 1999; 35(5):384-391.
- Wilkerson MJ, Davis E, Shuman W, et al.; Isotype-specific antibodies in horses and dogs with immune-mediated hemolytic anemia; Journal of Veterinary Internal Medicine; 2000; 14(5):456-462.
- Garden OA, Kidd L, Mexas AM, et al.; ACVIM consensus statement on the diagnosis of immune-mediated hemolytic anemia in dogs and cats; Journal of Veterinary Internal Medicine; 2019; 33(2):313-334.
- Arauz MS, Scodellaro CF, Pintos ME; Atlas de hematología veterinaria: Técnicas e interpretación del hemograma en pequeños animales; Universidad Nacional de La Plata; 2020.